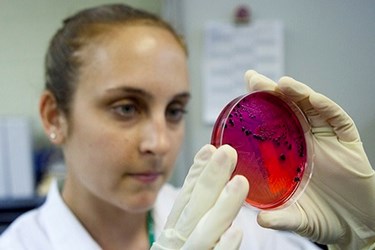
petri 1

Wastewater Chlorination May Birth Superbugs
Treated wastewater may contribute to the creation of superbugs, according to a study from researchers at UNC Charlotte.
“For decades, scientists have been investigating what effects drugs and other chemicals that get into wastewater may have on the environment and human health. More recently, they have become interested in how disinfection treatments can change them into new compounds. A new study suggests chlorination of wastewater may transform antibiotics into new forms,” Medical News Today reported.
The upshot is that these new forms of antibiotics appear to be “contributing to the development of antibiotic resistance in the environment,” according to The Charlotte Observer. Olya Keen, the head researcher on the project, explained the scary implications of this problem.
“Wastewater tests have found every type of antibiotic known,” she said. “The problems antibiotics cause when they are not broken down by treatment is they get into streams, where bacteria are becoming immune to them, and more dangerous, superbug, bacteria can be formed.”
The researchers are studying doxycycline, “which falls into one of the more widely used classes of antibiotics. Their research is showing that chlorine used to treat wastewater is actually changing the makeup of the doxycycline and forming new antibiotics,” the report said.
Keen explained: “Wastewater treatment is designed to break down biological substances, but not antibiotics. Surprisingly enough, though, we are finding in the lab that not only is chlorine not breaking down antibiotics, but it is actually creating even stronger antibiotics than the original doxycycline.”
Scientists were already aware of the link between antibiotics and wastewater. “For years scientists have been aware of the potential problems of antibiotics being present in wastewater,” the university explained. Nicole Kennedy-Neth,a doctoral student working on the project, placed that in context of the new findings.
“Antibiotics in wastewater are already impacting aquatic life,” she said. “This can lead to the development of antibiotic-resistant bacteria, which humans and animals may not be able to fight off. We’re hoping to eventually find better ways of breaking down the antibiotics during wastewater treatment, or developing preventative solutions to keep antibiotics out of wastewater in the first place.”
To read more of the latest wastewater treatment news, visit Water Online’s Wastewater Disinfection Solutions Center.
Image credit: "Working with Salmonella," News21 – National © 2011, used under an Attribution 2.0 Generic license: http://creativecommons.org/licenses/by/2.0/
Copyright © 1996 - 2015, VertMarkets, Inc. All rights reserved. To subscribe or visit go to: http://www.pollutiononline.com
http://www.pollutiononline.com/doc/wastewater-chlorination-may-birth-superbugs-0001